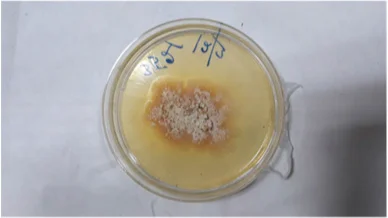

В Индии человек впервые заразился смертельным для деревьев грибком
31 марта, 06:59
Больше новостей
Выбор читателей
Самые популярные материалы за последние две недели 26–12 марта

Статьи
«Я им мешаю, потому что задаю вопросы»
Мэр и депутат судятся с пенсионеркой из Красноярского края из-за постов про состояние больницы и поездки на фронт. Прокуратура проверяет ее на «аморальное» поведение
Проект «Ветер»
10 марта, 16:12
Статьи
Кандидат от КСИР
На пост Верховного лидера Ирана претендует Моджтаба Хаменеи, сын убитого аятоллы. Он считается более радикальным, чем его отец, и тесно связан с силовиками. Что о нём известно?
Наталья Глухова
4 марта, 11:17
Статьи
Уроки Хаменеи
Ликвидация иранского лидера меняет систему ожиданий авторитарных элит в России и мире
Дмитрий Некрасов
2 марта, 11:24